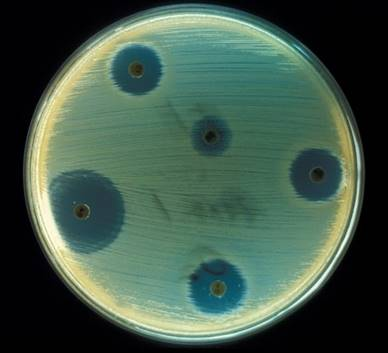
f:id:gomasan8:20211121085021p:plain

【中三応援プログラム】土の中の生物の働き(2013年滋賀県)
落ち葉の下の土とグランドの土の違いを調べる
【実験1】図1のように、落ち葉の下の土に水を加え、よくかき混ぜた後、ガーゼでこしたものを液体Aとした。同様に、グラウンドの土に水を加え、こしたものを液体Bとした。図2のように、 液体A, 液体Bを入れたペトリ皿に,根のついたほぼ同じ大きさのコダカラベンケイソウ(植物) を入れ,明るい部屋に置いた。2週間後,液体Aのコダカラベンケイソウの方が液体Bのものよ り大きくなっていた。

【実験2】実験1と同じ,落ち葉の下の土とグラウンドの土をステンレス皿に広げ,ガスバーナーで焼いた。焼く前と焼いた後の土のようすを観察し,質量を測定した。表1はその結果をまとめた ものである。

菌類はどれか(ペニシリンの話)
1 土の中の微生物である菌類はどれか。次のア~エから1つ選びなさい。
ア乳酸菌 イアオカビ ウ納豆菌 エゼニゴケ
分解者についての理解に関する問題である。
乳酸菌、納豆菌は細菌
ゼニゴケはコケ植物
アオカビが菌類である。
アオカビは、ブルーチーズを発酵させる菌である。ペニシリウム属のカビである。
![]()
www.j-cast.comより引用
土の中の微生物が細菌を殺す働きがあることで、その微生物が作り出す物質から抗生物質が取り出された。アオカビからから取り出されたのが、ペニシリンである。
ブドウ球菌の研究をしていたら、培養していたブドウ球菌に青カビが生えてしまうという実験で言うと大失敗をしてしまったわけです。
しかし、青カビの生えている所の周りのブドウ球菌は死んでいるということからアオカビの作る物質は菌を殺す力があるのではないかという考えからペニシリンを発見しました。
ペニシリンの発見は実験の失敗から生まれた、しかし、その失敗から新たな発見をしたのは普段さまざまなところにアンテナを伸ばしていたためといわれている。
奇跡の発見というのは突然やってくるものです。今でも、微生物が作り出す有用な物質、これを抗生物質という。これを探すために多くの土を研究している研究者がいる。
土の違いを燃やして調べる
2 実験1,2の結果から、グラウンドの土に比べ,落ち葉の下の土にはどのような違いがあると考 えられるか。次のア~エから1つ選びなさい。
ア焼いた後の土が,やや黒く、質量が大きいことから有機物が多い。
イ焼いた後の土が,黒くこげ,質量が小さいこと から有機物が少ない。
ウ焼いた後の土が,やや黒く,質量が大きいことから有機物が少ない。
エ焼いた後の土が,黒くこげ、質量が小さい ことから有機物が多い。
有機物は炭素を骨格としている。焼くと、炭素が黒く残る。
有機物を構成している物質は炭素のほかに酸素や水素が含まれているので、燃やすとそれらの物質がなくなり質量は小さくなる。
エが答えになる。
【実験3】図3のように,同じ量の液体A, 液体B, 液体Aを沸とうさせ冷ましたものを、それぞれ 別のピーカーに入れた。次に,それぞれのピーカーに,うすいデンプン溶液を同じ量ずつ入れ, 透明なフィルムでふたをし、暗い場所に置いた。
1週間後,気体検知管でピーカー内の二酸化 炭素の体積の割合を調べた。また,ピーカー内の液体にそれぞれヨウ素液を加え色の変化を調べた。表はその結果をまとめたものである。

3 実験3で,液体Aを沸とうさせ冷ましたものを用意した。沸とうさ せた理由は何か。書きなさい。
液体Aの微生物の働きを止めるため
呼吸はどの土の微生物が多く行うか。
4実験3の表2で,液体Aの二酸化炭素の体積の割合が、最も大きく なったのはなぜか。「呼吸」という語を使って説明しなさい。
液体Aの微生物がほかの液体よりも呼吸により、多くの有機物を分解して二酸化炭素にしたため
炭素の循環
5 図4は、自然界における炭素の循環を示したものである。図4をも とに,自然界における微生物と植物のつながりが、どのようになって いるかを説明しなさい。
